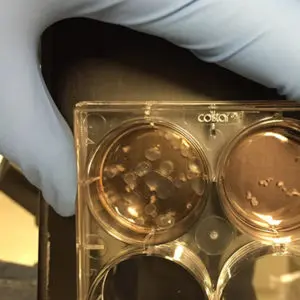

Your visionary support can power the development of innovative treatments and, eventually, cures for kidney disease. Here’s how your gift can help:
Accelerating
an End to
Kidney Disease
Rapid advances are being made in the treatment of kidney disease.
Yet, every year over 100,000 Americans experience kidney failure requiring dialysis or transplant.
Will you help us advance the groundbreaking research, care and education needed to develop new treatments and deliver hope and options to over 30 million Americans with kidney disease?
Your Impact
Accelerate breakthroughs in kidney research
Federal funding is very limited and often only available for selected diseases or treatments. Your bold support helps our researchers pursue the most innovative ideas to prevent and treat kidney disease.
Expand specialized kidney care for patients
Your gift helps us test interventions and provide more person-centered care that manages the symptoms of kidney failure and better aligns with patient goals and expectations.
Help develop a wearable kidney
Your generosity could free patients from a dialysis machine by helping the Center for Dialysis Innovation refine and commercialize their backpack-sized, portable artificial kidney.
Partner With a National Leader
in Kidney Care and Research
UW Medicine’s Division of Nephrology serves all patients with kidney disease, with expertise in in-center and home dialysis, chronic kidney disease including diabetic kidney disease, glomerular disease, hypertension, inherited kidney diseases, onco-nephrology, geriatrics and palliative care. Our renowned kidney transplant program is one of only four programs in the nation with higher-than-expected patient survival. And many of our researchers and physicians are national and international leaders in their fields.
Building upon Seattle’s history of leadership in kidney disease research, in 2008 UW Medicine and Northwest Kidney Centers founded the Kidney Research Institute — a leading clinical research endeavor focused on the early detection, prevention and treatment of kidney disease and its complications. A few years later, the two organizations launched the Center for Dialysis Innovation to catalyze innovation and improvements in dialysis therapy. Both teams are on the frontier of kidney disease research.
Stories
Join Us
Your thoughtful generosity will help us advance the most promising ideas in the prevention and treatment of kidney disease.
Will you help us fast-track new, better treatments and deliver more options to people living with kidney disease?